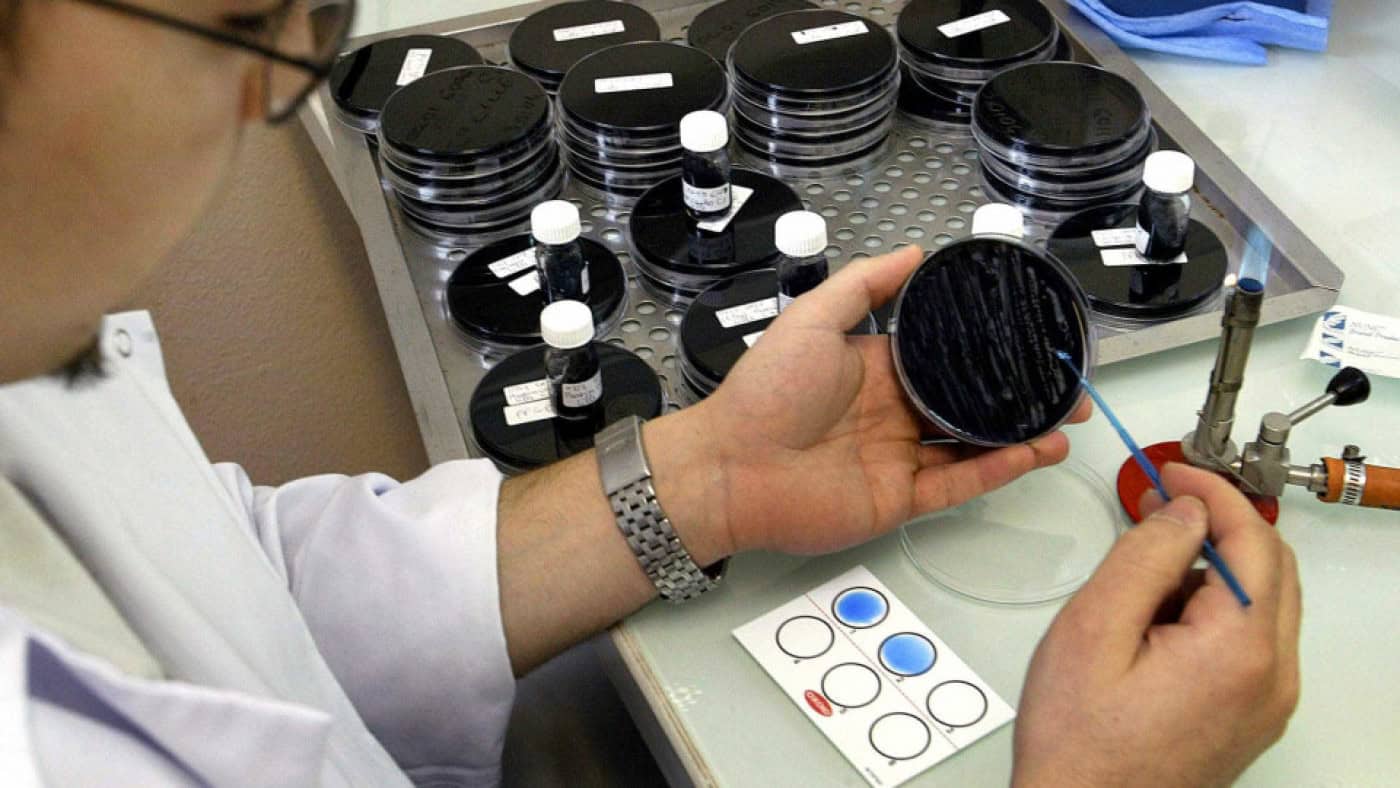
Sobe para oito o número de infetados por 'legionella' em Caminha

Sobe para oito o número de infetados por ‘legionella’ em Caminha
O número de infetados por ‘legionella’ no concelho de Caminha subiu para oito, tratando-se do quinto doente residente na freguesia de Vila Praia de Âncora, revelou hoje o município. A informação foi divulgada em comunicado pela Câmara de Caminha, no distrito de Viana do Castelo, no dia em as autoridades de Saúde da Xunta da Galicia revelaram à Lusa estar a estudar com Portugal a relação entre este surto e outro existente naquela região espanhola, onde foram identificados 10 casos de infeção pela bactéria.
Em Caminha, o caso hoje identificado diz respeito a uma mulher “de 83 anos, residente em Vila Praia de Âncora, que se encontra internada no hospital de Viana do Castelo, em situação estável”, informou a autarquia minhota. “Até ao momento há oito casos referenciados e duas das pessoas que tinham sido internadas já tiveram alta”, acrescentou.
A Câmara de Caminha indicou ainda que se realizou hoje “uma reunião de trabalho entre os serviços de saúde de Portugal e de Espanha, fruto do surgimento de ‘legionella’ na raia transfronteiriça”. A investigação ambiental sobre a origem do surto em Caminha “prossegue, sem conclusões até ao momento”. Desde quinta-feira que não eram identificados novos casos de ‘legionella’ no concelho de Caminha, distrito de Viana do Castelo.
O primeiro doente de Caminha infetado com ‘legionella’ foi notificado às autoridades de saúde no dia 10 de novembro e o sétimo na quarta-feira, dia 15. Cinco dos infetados residem em Vila Praia de Âncora, dois em Moledo e um em Vilarelho, naquele concelho.
O departamento de Saúde da Xunta da Galicia revelou hoje estar a colaborar com Portugal na investigação dos casos de ‘legionella’ naquela região espanhola e no concelho de Caminha, visando apurar se os casos identificados estão relacionados.
“Os especialistas vão analisar e sequenciar as amostras recolhidas nas localidades afetadas para determinar se têm relação”, informa a Conselleria de Saúde da Xunta da Galicia, em Espanha, numa nota de imprensa enviada à Lusa
A instituição acrescenta que a equipa da Direção Geral de Saúde Pública se reuniu “com os homólogos em Portugal para trocar informações sobre os casos de ‘legionella’ galega e os detetados no Norte de Portugal, especificamente na cidade de Caminha”.´
“Ainda não é possível concluir qual a fonte de exposição” à bactéria da ‘legionella’, refere a Conselleria, recordando que “o contágio ocorre, geralmente, por meio de aerossóis”. Dez pessoas estão infetadas com ‘legionella’ nos municípios de A Guarda e O Rosal, na Galiza. De acordo com a Conselleria de Saúde, relativamente ao décimo caso, identificado hoje, os “sintomas surgiram há pelo menos uma semana”.
A Conselleria de Saúde refere que sete pessoas residentes naqueles municípios galegos permanecem hoje hospitalizadas devido à infeção por ‘legionella’. Foi iniciada uma investigação ambiental, com recolha de amostras de água das zonas onde residem as pessoas afetadas na Galiza, assim como do domicílio de cinco delas, mas os resultados “foram negativos”.
A Guarda fica em frente ao concelho de Caminha, onde um surto de ‘legionella’ tornado público no dia 14 infetou oito pessoas. Os dois municípios estão separados por cerca de seis quilómetros e pelo rio Minho, não existindo uma ligação direta entre as duas margens.
A doença do legionário, provocada pela bactéria ‘Legionella pneumophila’, contrai-se por inalação de gotículas de vapor de água contaminada (aerossóis) de dimensões tão pequenas que transportam a bactéria para os pulmões, depositando-a nos alvéolos pulmonares.
LUSA
